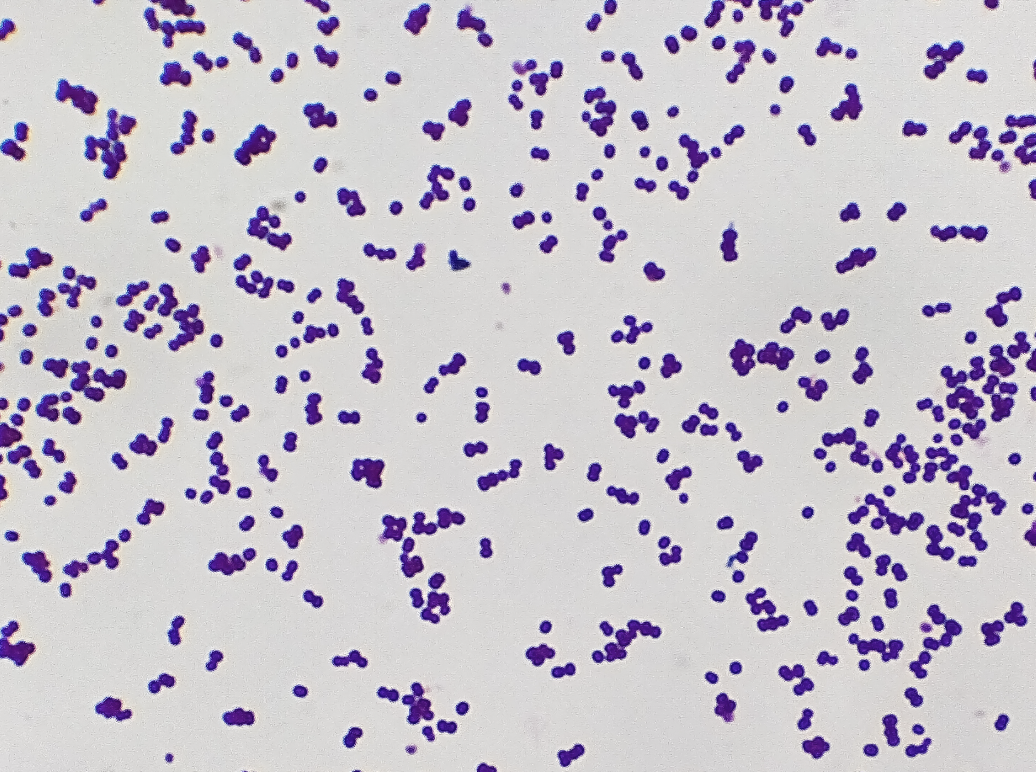

All staphylococci are _ and _
All staphylococci are gram-positive cocci in clusters
All staph are gram-postive, and _ positive
All staph are gram-postive, and catalase positive
Not all staph are coagulase positive; specifically _ is coagulase positive
Not all staph are coagulase positive; specifically S aureus is coagulase positive
S. aureus characteristics
S. aureus
* Gram positive cocci, catalase positive, grows on mannitol salt
* Coagulase positive
* Beta hemolytic
* Yellow/gold hue on plates
Gram-positive cocci, gamma-hemolytic, coagulase negative, novobiocin sensitive
Gram-positive cocci, gamma-hemolytic, coagulase negative, novobiocin sensitive: s. epidermidis
Gram positive cocci, gamma hemolytic, coagulase negative, novobiocin resistant
Gram positive cocci, gamma hemolytic, coagulase negative, novobiocin resistant: s. saprophyticus
Associated with colonization of foreign objects due to biofilm formation
Associated with colonization of foreign objects due to biofilm formation: S epidermidis
Normal inhabitant of GU and GI tracts and common cause of UTI
Normal inhabitant of GU and GI tracts and common cause of UTI: s saprophyticus
Gram positive cocci in chains, catalase negative, alpha hemolytic
Gram positive cocci in chains, catalase negative, alpha hemolytic: strep. pneumoniae, strep. viridans
Gram positive cocci in chains, catalase negative, beta hemolytic
Gram positive cocci in chains, catalase negative, beta hemolytic: strep. pyogenes, strep. agalactiae
Gram positive cocci in chains, catalase negative, gamma hemolytic
Gram positive cocci in chains, catalase negative, gamma hemolytic: e. faecalis
S. pyogenes (Group A strep) is novobiocin (sensitive/ resistance)
S. pyogenes (Group A strep) is novobiocin- sensitive
Rheumatic fever develops because of antibodies to _ cross-react with _
Rheumatic fever develops because of antibodies to GAS “M” protein cross-react with myosin
Within the viridans family, _ , _ , and _ are all associated with subacute infective endocarditis following dental procedures
Within the viridans family, s. mutans, s. sanguinis and s mitis are all associated with subacute infective endocarditis following dental procedures
_ is the most common cause of acute infection of native, healthy heart valves; associated with IV drug use
S. aureus is the most common cause of acute infection of native, healthy heart valves; associated with IV drug use
_ is the most common cause of subacute infection of damaged heart valves; can travel from oral cavity during dental procedures
Viridans is the most common cause of subacute infection of damaged heart valves; can travel from oral cavity during dental procedures
_ is most common infection of prosthetic heart valves
S. epidermidis is most common infection of prosthetic heart valves
The most common sx of infective endocarditis is _
The most common sx of infective endocarditis is fever
IE post dental procedure but the causative organism takes 4 days to grow on plates:
IE post dental procedure but the causative organism takes 4 days to grow on plates: HACEK
Pathogenesis of IE on a healthy, normal valve
(Endothelial) injury to the valve –>
Fibrin thrombus –>
Transient bacteremia –>
Bacteria adhere and colonize fibrin –>
Acute inflammation
Necrosis of the valve is possible
Criteria for making IE diagnosis

Nonbacterial thrombotic endocarditis is likely caused by increased _ in patients with conditions such as _
Nonbacterial thrombotic endocarditis is likely caused by increased hypercoagulability in patients with conditions such as Lupus, APS syndrome, Cancer
* Sterile fibrin vegetations form
* Can get infarctions from emboli
* Treatment: anticoagulate
Nonbacterial thrombotic endocarditis usually targets _ valves
Nonbacterial thrombotic endocarditis usually targets mitral and aortic valves
How do we diagnose rheumatic fever?
Jones criteria
J: joints (polyarthritis)
A: heart (pancarditis)
N: nodules
E: erythema marginatum
S: sydenham chorea



